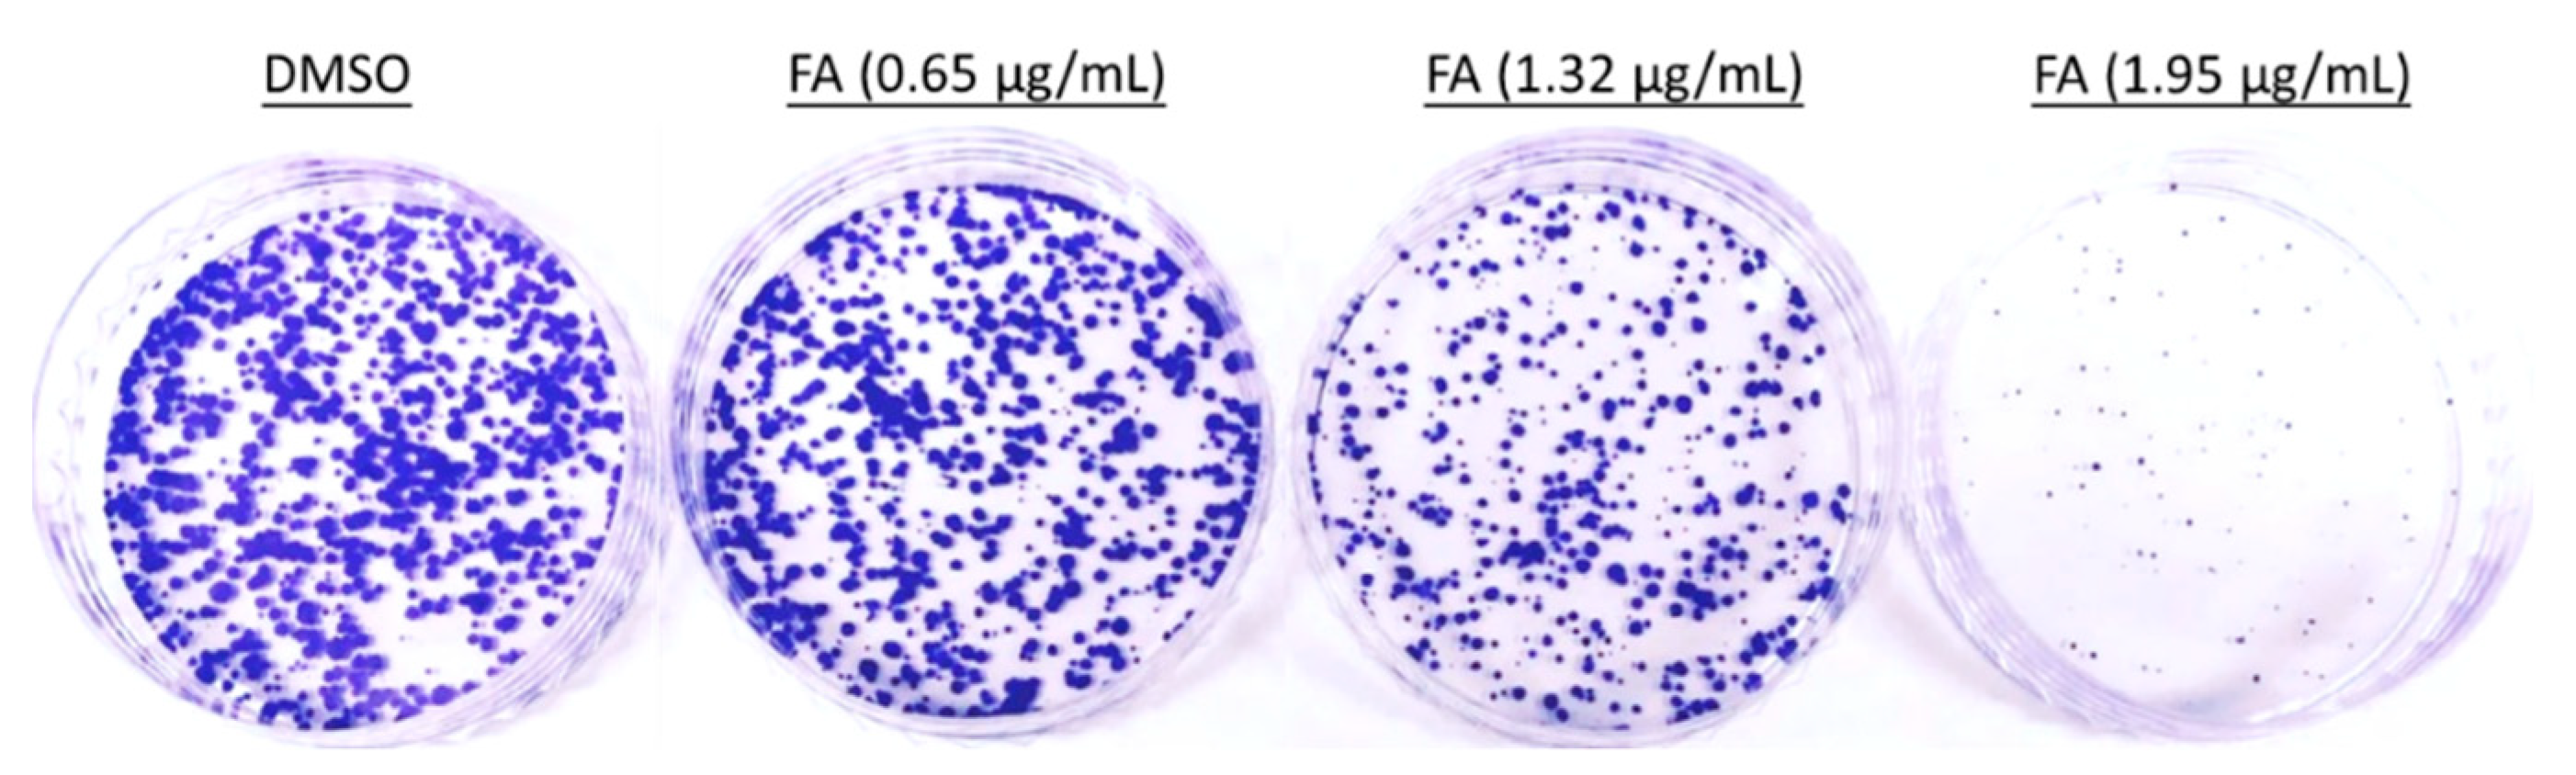
Ijms 20 01917 g002

Flexicaulin A, An ent-Kaurane Diterpenoid, Activates p21 and Inhibits the Proliferation of Colorectal Carcinoma Cells through a Non-Apoptotic Mechanism
Abstract
1. Introduction
2. Results
2.1. Flexicaulin A Treatment Inhibits Carcinoma Cell Proliferation
2.2. Flexicaulin A Treatment Induces Cell Cycle Arrest
2.3. Flexicaulin A Targets the p53/p21 Signaling Pathway
2.4. Flexicaulin A Treatment Reduces Tumor Development in A Colorectal Carcinoma Xenograft Model
3. Discussion
4. Materials and Methods
4.1. Materials
4.2. Cell lines and Culture Condition
4.3. Cell Viability Assay
4.4. Colony Formation Assay
4.5. Flow Cytometric Analyses
4.6. Senescence-Associated β-Galactosidase (SA-β-gal) Colorimetric Assay
4.7. Quantitative Polymerase Chain Reaction (qPCR) Arrays
4.8. Western Blot Analysis
4.9. Immunofluorescent Staining
4.10. Colorectal Carcinoma Xenograft Model
4.11. Statistical Analysis
5. Conclusions
Author Contributions
Funding
Conflicts of Interest
Abbreviations
| 5-FU | 5-fluorouracil |
| DAPI | 4′,6-diamidino-2-phenylindole |
| DMSO | dimethylsulfoxide |
| FA | flexicaulin A |
| PTX | paclitaxel |
| qPCR | quantitative polymerase chain reaction |
| SA-β-gal | senescence-associated β-galactosidase |
| SRB | sulforhodamine B |
References
- World Health Organization (WHO). Fact Sheets: Cancer; WHO: Geneva, Switzerland, 2018; Available online: http://www.who.int/mediacentre/factsheets/fs297/en/ (accessed on 28 December 2018).
- Lowe, S.W.; Lin, A.W. Apoptosis in cancer. Carcinogenesis 2000, 21, 485–495. [Google Scholar] [CrossRef] [PubMed]
- Herr, I.; Debatin, K.M. Cellular stress response and apoptosis in cancer therapy. Blood 2001, 98, 2603–2614. [Google Scholar] [CrossRef]
- Barnum, K.J.; O’Connell, M.J. Cell cycle regulation by checkpoints. Methods Mol. Biol. 2014, 1170, 29–40. [Google Scholar] [PubMed]
- Malumbres, M.; Barbacid, M. To cycle or not to cycle: A critical decision in cancer. Nat. Rev. Cancer 2001, 1, 222–231. [Google Scholar] [CrossRef] [PubMed]
- Funk, J.O. Cell Cycle Checkpoint Genes and Cancer; eLS: Chicago, IL, USA, 2006. [Google Scholar] [CrossRef]
- Gartel, A.L.; Tyner, A.L. Transcriptional regulation of the p21(WAF1/CIP1) gene. Exp. Cell Res. 1999, 246, 280–289. [Google Scholar] [CrossRef]
- Dotto, G.P. p21(WAF1/Cip1): More than a break to the cell cycle? Biochim. Biophys. Acta 2000, 1471, M43–M56. [Google Scholar]
- Xiong, Y.; Hannon, G.J.; Zhang, H.; Casso, D.; Kobayashi, R.; Beach, D. p21 is a universal inhibitor of cyclin kinases. Nature 1993, 366, 701–704. [Google Scholar] [CrossRef]
- Waga, S.; Hannon, G.J.; Beach, D.; Stillman, B. The p21 inhibitor of cyclin dependent kinases controls DNA replication by interaction with PCNA. Nature 1994, 369, 574–578. [Google Scholar] [CrossRef]
- Warbrick, E.; Lane, D.P.; Glover, D.M.; Cox, L.S. A small peptide inhibitor of DNA replication defines the site of interaction between the cyclin-dependent kinase inhibitor p21WAF1 and proliferating cell nuclear antigen. Curr. Biol. 1995, 5, 275–282. [Google Scholar] [CrossRef]
- Abbas, T.; Dutta, A. p21 in cancer: Intricate networks and multiple activities. Nat. Rev. Cancer 2009, 9, 400–414. [Google Scholar] [CrossRef] [PubMed]
- Newman, D.J.; Cragg, G.M. Natural products as sources of new drugs over the last 30 years from 1981 to 2010. J. Nat. Prod. 2012, 75, 311–335. [Google Scholar] [CrossRef]
- Pereira, D.M.; Valentao, P.; Correia-da-Silva, G.; Teixeira, N.; Andrade, P.B. Plant secondary metabolites in cancer chemotherapy: Where are we? Curr. Pharm. Biotechnol. 2012, 5, 632–650. [Google Scholar] [CrossRef]
- Wang, L.; Li, D.; Wang, C.; Zhang, Y.; Xu, J. Recent progress in the development of natural ent-kaurane diterpenoids with anti-tumor activity. Mini-Rev. Med. Chem. 2011, 11, 910–919. [Google Scholar] [CrossRef]
- Zhang, H.J.; Sun, H.D. Diterpenoids from Rabdosia flexicaulis. Phytochemistry 1989, 28, 3534–3536. [Google Scholar]
- Sun, H.D.; Huang, S.X.; Han, Q.B. Diterpenoids from Isodon species and their biological activities. Nat. Prod. Rep. 2006, 23, 673–698. [Google Scholar] [CrossRef] [PubMed]
- Pfeffer, C.M.; Singh, A.T.K. Apoptosis: A Target for Anticancer Therapy. Int. J. Mol. Sci. 2018, 19, 448. [Google Scholar] [CrossRef]
- Strasser, A.; Cory, S.; Adams, J.M. Deciphering the rules of programmed cell death to improve therapy of cancer and other diseases. EMBO J. 2011, 30, 3667–3683. [Google Scholar] [CrossRef] [PubMed]
- Fernald, K.; Kurokawa, M. Evading apoptosis in cancer. Trends Cell Biol. 2013, 23, 620–633. [Google Scholar] [CrossRef]
- Sargent, D.; Sobrero, A.; Grothey, A.; O’Connell, M.J.; Buyse, M.; Andre, T.; Zheng, Y.; Green, E.; Labianca, R.; O’Callaghan, C.; et al. Evidence for cure by adjuvant therapy in colon cancer: Observations based on individual patient data from 20,898 patients on 18 randomized trials. J. Clin. Oncol. 2009, 27, 872–877. [Google Scholar] [CrossRef]
- Bailon-Moscoso, N.; Cevallos-Solorzano, G.; Romero-Benavides, J.C.; Orellana, M.I. Natural compounds as modulators of cell cycle arrest: Application for anticancer chemotherapies. Curr. Genomics 2017, 18, 106–131. [Google Scholar] [CrossRef]
- Ravizza, R.; Gariboldi, M.B.; Passarelli, L.; Monti, E. Role of the p53/p21 system in the response of human colon carcinoma cells to Doxorubicin. BMC Cancer 2004, 4, 92. [Google Scholar] [CrossRef] [PubMed]
- Satou, M.; Aizawa, S.; Hayakari, M.; Ookawa, K.; Tsuchida, S. Enhanced sensitivity to cis-diamminedichloroplatinum(II) of a human carcinoma cell line with mutated p53 gene by cyclin-dependent kinase inhibitor p21(WAF1) expression. Cancer Sci. 2003, 94, 286–291. [Google Scholar] [CrossRef] [PubMed]
- Bunz, F.; Hwang, P.M.; Torrance, C.; Waldman, T.; Zhang, Y.; Dillehay, L.; Williams, J.; Lengauer, C.; Kinzler, K.W.; Vogelstein, B. Disruption of p53 in human cancer cells alters the response to therapeutic agents. J. Clin. Investig. 1999, 104, 263–267. [Google Scholar] [CrossRef]
- Lu, Y.; Chen, B.; Song, J.H.; Zhen, T.; Wang, B.Y.; Li, X.; Liu, P.; Yang, X.; Zhang, Q.L.; Xi, X.D.; et al. Eriocalyxin B ameliorates experimental autoimmune encephalomyelitis by suppressing Th1 and Th17 cells. Proc. Natl. Acad. Sci. USA 2013, 110, 2258–2263. [Google Scholar] [CrossRef] [PubMed]
- Dolcet, X.; Llobet, D.; Pallares, J.; Matias-Guiu, X. NF-κB in development and progression of human cancer. Virchows Arch. 2005, 446, 475–482. [Google Scholar] [CrossRef] [PubMed]
- Nassier, O.A. Protein undernutrition in tumor-bearing mice, response and toxicity to paclitaxel. Int. J. Pharmacol. 2010, 6, 296–300. [Google Scholar] [CrossRef]
- Xu, X.Y.; Tsang, S.W.; Guan, Y.F.; Liu, K.L.; Pan, W.H.; Lam, C.S.; Lee, K.M.; Xia, Y.X.; Xie, W.J.; Wong, W.Y.; et al. In vitro and in vivo antitumor effects of plant-derived miliusanes and their induction of cellular senescence. J. Med. Chem. 2019. [Google Scholar] [CrossRef] [PubMed]
- Guo, L.; Tsang, S.W.; Zhang, T.X.; Liu, K.L.; Guan, Y.F.; Wang, B.; Sun, H.D.; Zhang, H.J.; Wong, M.S. Efficient semisynthesis of (-)-pseudoirroratin A from (-)-flexicaulin A and assessment of their antitumor activities. ACS Med. Chem. Lett. 2017, 8, 372–376. [Google Scholar] [CrossRef]

| Symbol | Well | Fold Change |
|---|---|---|
| Test Sample/Control Sample | ||
| ABL1 | A01 | 1.157 |
| AKT1 | A02 | 1.309 |
| ALDH1A3 | A03 | 0.989 |
| ATM | A04 | 1.199 |
| BMI1 | A05 | 1.657 |
| CALR | A06 | 1.270 |
| CCNA2 | A07 | 1.076 |
| CCNB1 | A08 | 0.966 |
| CCND1 | A09 | 1.597 |
| CCNE1 | A10 | 1.696 |
| CD44 | A11 | 1.169 |
| CDC25C | A12 | 0.966 |
| CDK2 | B01 | 1.124 |
| CDK4 | B02 | 0.946 |
| CDK6 | B03 | 1.117 |
| CDKN1A | B04 | 2.305 |
| CDKN1B | B05 | 1.045 |
| CDKN1C | B06 | 1.001 |
| CDKN2A | B07 | 0.965 |
| CDKN2B | B08 | 1.119 |
| CDKN2C | B09 | 0.898 |
| CDKN2D | B10 | 1.068 |
| CHEK1 | B11 | 0.975 |
| CHEK2 | B12 | 1.173 |
| CITED2 | C01 | 0.950 |
| COL1A1 | C02 | 1.754 |
| COL3A1 | C03 | 3.141 |
| CREG1 | C04 | 1.024 |
| E2F1 | C05 | 0.940 |
| E2F3 | C06 | 1.110 |
| EGR1 | C07 | 1.797 |
| ETS1 | C08 | 1.353 |
| ETS2 | C09 | 1.019 |
| FN1 | C10 | 0.766 |
| GADD45A | C11 | 1.265 |
| GLB1 | C12 | 1.172 |
| GSK3B | D01 | 1.262 |
| HRAS | D02 | 1.172 |
| ID1 | D03 | 1.013 |
| IFNG | D04 | 1.514 |
| IGF1 | D05 | 1.514 |
| IGF1R | D06 | 0.950 |
| IGFBP3 | D07 | 2.957 |
| IGFBP5 | D08 | 1.361 |
| IGFBP7 | D09 | 1.561 |
| ING1 | D10 | 0.931 |
| IRF3 | D11 | 1.291 |
| IRF5 | D12 | 1.316 |
| IRF7 | E01 | 1.721 |
| MAP2K1 | E02 | 1.675 |
| MAP2K3 | E03 | 1.262 |
| MAP2K6 | E04 | 1.144 |
| MAPK14 | E05 | 1.264 |
| MDM2 | E06 | 1.710 |
| MORC3 | E07 | 1.409 |
| MYC | E08 | 1.059 |
| NBN | E09 | 1.199 |
| NFKB1 | E10 | 1.266 |
| NOX4 | E11 | 1.514 |
| PCNA | E12 | 1.216 |
| PIK3CA | F01 | 1.185 |
| PLAU | F02 | 1.181 |
| PRKCD | F03 | 1.416 |
| PTEN | F04 | 1.179 |
| RB1 | F05 | 1.205 |
| RBL1 | F06 | 1.122 |
| RBL2 | F07 | 1.271 |
| SERPINB2 | F08 | 1.893 |
| SERPINE1 | F09 | 2.258 |
| SIRT1 | F10 | 1.317 |
| SOD1 | F11 | 1.193 |
| SOD2 | F12 | 1.089 |
| SPARC | G01 | 1.514 |
| TBX2 | G02 | 1.514 |
| TBX3 | G03 | 1.841 |
| TERF2 | G04 | 1.344 |
| TERT | G05 | 1.772 |
| TGFB1 | G06 | 1.581 |
| TGFB1I1 | G07 | 1.553 |
| THBS1 | G08 | 1.104 |
| TP53 | G09 | 1.036 |
| TP53BP1 | G10 | 1.075 |
| TWIST1 | G11 | 1.785 |
| VIM | G12 | 0.662 |
| ACTB | H01 | 1.069 |
| B2M | H02 | 0.945 |
| GAPDH | H03 | 0.900 |
| HPRT1 | H04 | 1.085 |
| RPLP0 | H05 | 0.955 |
© 2019 by the authors. Licensee MDPI, Basel, Switzerland. This article is an open access article distributed under the terms and conditions of the Creative Commons Attribution (CC BY) license (http://creativecommons.org/licenses/by/4.0/).
Share and Cite
Xia, Y.; Lam, C.S.; Li, W.; Sarwar, M.S.; Liu, K.; Lee, K.M.; Zhang, H.-J.; Tsang, S.W. Flexicaulin A, An ent-Kaurane Diterpenoid, Activates p21 and Inhibits the Proliferation of Colorectal Carcinoma Cells through a Non-Apoptotic Mechanism. Int. J. Mol. Sci. 2019, 20, 1917. https://doi.org/10.3390/ijms20081917
Xia Y, Lam CS, Li W, Sarwar MS, Liu K, Lee KM, Zhang H-J, Tsang SW. Flexicaulin A, An ent-Kaurane Diterpenoid, Activates p21 and Inhibits the Proliferation of Colorectal Carcinoma Cells through a Non-Apoptotic Mechanism. International Journal of Molecular Sciences. 2019; 20(8):1917. https://doi.org/10.3390/ijms20081917
Chicago/Turabian StyleXia, Yixuan, Chu Shing Lam, Wanfei Li, Md. Shahid Sarwar, Kanglun Liu, Kwan Ming Lee, Hong-Jie Zhang, and Siu Wai Tsang. 2019. "Flexicaulin A, An ent-Kaurane Diterpenoid, Activates p21 and Inhibits the Proliferation of Colorectal Carcinoma Cells through a Non-Apoptotic Mechanism" International Journal of Molecular Sciences 20, no. 8: 1917. https://doi.org/10.3390/ijms20081917
APA StyleXia, Y., Lam, C. S., Li, W., Sarwar, M. S., Liu, K., Lee, K. M., Zhang, H.-J., & Tsang, S. W. (2019). Flexicaulin A, An ent-Kaurane Diterpenoid, Activates p21 and Inhibits the Proliferation of Colorectal Carcinoma Cells through a Non-Apoptotic Mechanism. International Journal of Molecular Sciences, 20(8), 1917. https://doi.org/10.3390/ijms20081917

